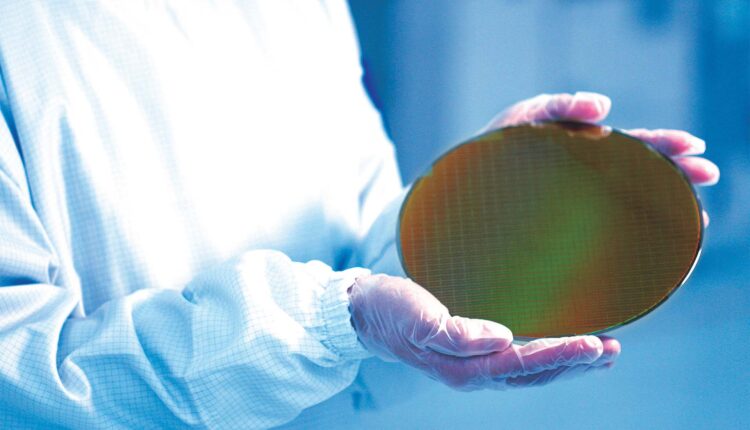

Samsung Foundry intensifie ses efforts pour rendre son processus de fabrication en 2 nm compétitif sur le marché. Dans cette optique, la division s’engage à améliorer ses installations et à moderniser ses chaînes de production.
La détermination de Samsung face aux défis du marché des semi-conducteurs
Malgré des conditions difficiles, le géant coréen continue de viser l’excellence dans la course aux semi-conducteurs. Les produits en 3 nm, censés représenter une révolution grâce à l’intégration de la technologie GAA, n’ont pas suscité l’intérêt escompté. Cette situation a provoqué des pertes financières considérables pour \(Samsung\). Le processus en 2 nm semble suivre une trajectoire similaire, malgré un avantage sur TSMC en taille de nœud.
Selon un communiqué récent de BusinessKorea, Samsung Foundry procède actuellement à la production de masse en 2 nm, en établissant des installations de pointe sur son site de Hwaseong, en Corée du Sud. L’objectif est d’atteindre une production de 7 000 plaquettes par mois d’ici le premier trimestre de 2025. Mais ce ne sont pas seulement les 2 nm qui sont au programme : Samsung se projette également vers le 1.4 nm, avec des projets d’extension de lignes de production à l’usine Pyeongtaek 2, capable de traiter jusqu’à 3 000 wafettes.

Samsung vise directement à concurrencer le cycle de production de TSMC, avec l’ambition de devancer cette entreprise en accélérant le processus de réduction de nœud. En entamant des travaux sur le 2 nm et en se préparant à passer au 1.4 nm prochainement, Samsung pourrait possiblement devancer TSMC de deux ans, sachant que la firme taïwanaise n’envisage le 1.4 nm qu’en 2027. Lors d’une récente conférence sur les résultats, la direction de Samsung a exprimé sa pleine confiance en sa division de fonderie, écartant les rumeurs de scission potentielle.
Il est crucial de noter que l’accent mis par Samsung sur la réduction des nœuds pourrait rencontrer des difficultés. En effet, les technologies existantes, notamment celles en 3 nm, souffrent de taux de rendement instables, rendant la production inefficace. En comparaison, TSMC bénéficie d’une forte demande pour ses nœuds de 3 nm et ses dérivés, soulignant les défis à surmonter pour Samsung dans sa stratégie de réduction de nœud.
Pour l’heure, Samsung devra surmonter un chemin semé d’embûches avant de rivaliser efficacement avec TSMC. L’importance des taux de rendement stables est primordiale pour l’adoption généralisée d’une technologie. Malgré cela, l’entreprise garde espoir dans sa quête du trône de TSMC, laissant le temps déterminer l’issue de cette compétition.